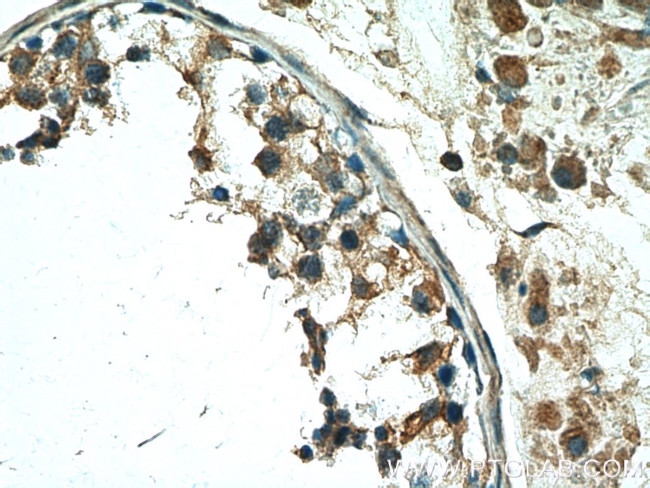
TSGA10 Antibody in Immunohistochemistry (Paraffin) (IHC (P))
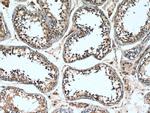
TSGA10 Antibody in Immunohistochemistry (Paraffin) (IHC (P))

Search
Proteintech
TSGA10 Polyclonal Antibody
{{$productOrderCtrl.translations['antibody.pdp.commerceCard.promotion.promotions']}}
{{$productOrderCtrl.translations['antibody.pdp.commerceCard.promotion.viewpromo']}}
{{$productOrderCtrl.translations['antibody.pdp.commerceCard.promotion.promocode']}}: {{promo.promoCode}} {{promo.promoTitle}} {{promo.promoDescription}}. {{$productOrderCtrl.translations['antibody.pdp.commerceCard.promotion.learnmore']}}
产品信息
12593-1-AP
种属反应
已发表种属
宿主/亚型
分类
类型
抗原
偶联物
形式
浓度
规格
纯化类型
保存液
内含物
保存条件
运输条件
产品详细信息
Immunogen sequence: LEVNKLKNI LKSEESENRQ MMEQLRKANE DAENWENKAR QSEADNNTLK LELITAEAEG NRLKEKVDSL NREVEQHLNA ERSYKSQIST LHKSVVKMEE ELQKVQFEKV SALADLSSTR ELCIKLDSSK ELLNRQLVAK DQEIEMRENE LDSAHSEIEL LRSQMANERI SMQNLEALLV ANRDKEYQSQ IALQEKESEI QLLKEHLCLA ENKMAIQSRD VAQFRNVVTQ LEADLDITKR QLGTERFERE RAVQELRRQN YSSNAYHMSS TMKPNTKCHS PERAHHRSPD RGLDRSLEEN LCYRDF (394-698 aa encoded by BC028366)
靶标信息
TSGA10 may play a role in the sperm tail fibrous sheath, a major sperm tail structure.
仅用于科研。不用于诊断过程。未经明确授权不得转售。
生物信息学
蛋白别名: cancer/testis antigen 79; cp431; Testis development protein NYD-SP7; testis-specific 10 protein; Testis-specific gene 10 protein; unnamed protein product
基因别名: 4933432N21Rik; AI843383; CEP4L; CT79; Gm217; Mtsga10; SPGF26; TSGA10
UniProt ID: (Human) Q9BZW7, (Mouse) Q6NY15
Entrez Gene ID: (Human) 80705, (Mouse) 211484, (Rat) 252923